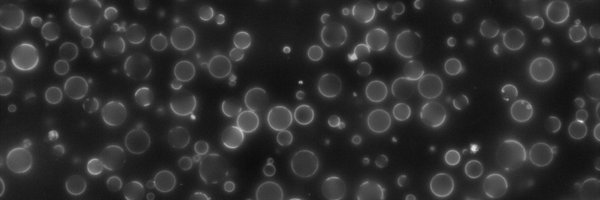
VeatchLab Profile Banner

Sarah Veatch
@VeatchLab
Followers
696
Following
118
Media
28
Statuses
85
membrane biophysics lab, interested in the role that phase-mediated heterogeneity plays in signaling processes @ the plasma membrane.
University of Michigan
Joined January 2020
The wall celebrating veatchlab alums is up just in time for the start of the academic year at @UMBiophys including a few new ones representing @ss_shelbs , @suminkim28, and Thomas Shaw. Your impact looms large.
4
2
52
Apply to be my colleague in biophysics at Michigan! We are a vibrant small program in a large and resource-rich university. We are looking for applications at the assistant prof and newly minted associate prof levels. Reach out with ?s if interested.
Colleagues note: Michigan Biophysics through the LSA Collegiate Fellows Program aims to recruit and hire exceptional tenure-track assistant and new tenured associate professors to promote an inclusive scholarly environment. Deadlines and requirements. https://t.co/Z9nHjAUdGK.
0
23
29
Introducing Dr. Thomas Shaw! Congrats to Thomas for a great talk and thesis -- and check out that cake made by veatchlab members and alums including @ss_shelbs @AdamDecker98 @JenChemFlan inspired by a figure made by @biophysnerd!
3
5
37
What he said! This piece does a particularly good job summarizing @ss_shelbs observations of tunable domain contrast at BCR clusters.
Neat, quick summary of beautiful recent paper by @VeatchLab and @ss_shelbs. Will only take you 2min to read... but be warned, you'll then want to read the whole paper.
0
0
4
This one has been in the works for a long time! Thanks to the many people that made it possible: Of course our co-authors Kathleen Wisser, @Ivanubis84, and @leventallab. Also thanks to @uiztok, @AgEggeling, and @Sciezgin for the News & Views shoutout!
1
4
19
For some more perspective, we recently published a short review summarizing how we are thinking about phases, rafts, and the incredible things that membranes can do. https://t.co/nqottKyBea
1
0
12
Takeaway: we think that these domains at BCR clusters have tunable contrast because they integrate both the stimulus (related to proteins brought to the domain through protein interactions) and the membrane thermodynamics (how close the membrane is to its phase transition).
1
0
4
Not only did this manipulate how anchors sort w/r/t BCR clusters, it also tuned the magnitude of BCR Tyr phosphorylation! This nicely corroborates existing work implicating lipid rafts in BCR activation, now w/ a direct connection to the underlying membrane phase transition.
1
0
2
We tuned contrast two ways: first by co-clustering BCR with minimal “co-receptors” to alter the stimulus, and second by adding hydrophobic small molecules to manipulate membrane thermodynamics by shifting the phase transition temperature.
2
0
3
Now for that twist: we noticed that these domains at BCR clusters sort anchors less strongly than phases in vesicles. In other words, domains in cells have lower “contrast” than ordered domains in phase separated vesicles. Maybe contrast can be tuned?
1
0
3
Seeing these relationships was made possible by quantitative methods described in the paper and in an upcoming methods chapter (more deets soon!). Code and sample scripts posted here:
github.com
Contribute to VeatchLab/smlm-analysis development by creating an account on GitHub.
1
0
2
We can also look at anchor dynamics, and anchor confinement near BCR clusters is also strongly correlated with partitioning in vesicles. Conclusion: the membrane phase transition drives both the concentration and retention of membrane components within domains.
1
0
2
They agree very well! Anchor partitioning between vesicle phases quantitatively predicts anchor concentration near BCR clusters. Conclusion: membrane phase separation is a physical driver of domain formation around clustered BCRs.
1
0
4
At the same time, our awesome collaborators in @leventallab measured partitioning of the same anchors in phase-separated giant plasma membrane vesicles (GPMVs). Both measurements basically quantify local concentration of anchors, so we can compare them directly. When we do…
1
0
4
To answer that, we went with a brute force approach: In super-res experiments, we looked at co-localization of a whole bunch of probes with BCR clusters. These are all minimal membrane anchors -- from peripheral or transmembrane proteins, w/ and w/out various acylations, etc.
1
0
3
Some kind of structure forms in the membrane around BCR clusters as they assemble. This domain can locally concentrate one probe and deplete another, depending on the identity of its lipid anchors. But what is this domain and how/why does it form?
1
0
3
We used multicolor STORM/PALM to visualize interactions btwn B cell receptors and membrane probes in live cells. We looked at how probes – which are just membrane protein anchor motifs attached to fluorescent proteins – distribute around BCR clusters.
1
1
7
Announcing our publication featuring Sarah Shelby @ss_shelbs with @leventallab in @nchembio! https://t.co/bjXsE6zXEi or https://t.co/6YcdBjtZLT TLDR: functional lipid rafts driven by membrane phase separation exist in live cell membranes, but with an unexpected twist! #lipidtime
8
36
155
This is part of a special issue in honor of Klaus Gawrisch, a legend in membrane biophysics and great mentor and friend. Check out this great write-up in the issue:
0
0
5